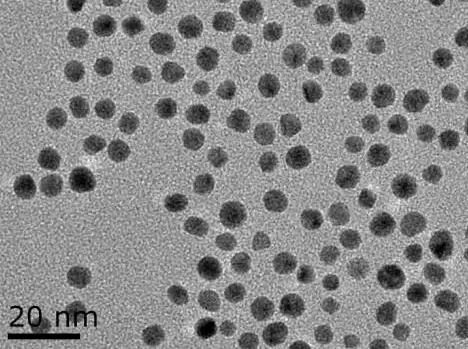

金纳米晶诱导(修饰|链接)双巯基偶氮苯/Azobenzene复合定制材料
巯基偶氮苯的定制
4,4'-二巯基偶氮苯及其制备方法,涉及一种偶氮类巯基化合物.4,4'-二巯基偶氮苯的分子式HS(C6H4)N=N(C6H4)SH.
步骤一:将苯胺溶于碳酸氢钠的水溶液中,
步骤二:加入I2反应后,减压抽干溶剂得4-碘苯胺,
步骤三:再溶于冰醋酸,加入NaBO3·4H2O和H3BO3反应后,用THF重结晶得4,4'-二碘偶氮苯,
步骤四:溶于THF中,分批加到镁屑中反应后,冷却得偶氮苯格氏试剂;
步骤五:将固体硫粉分批加入到偶氮苯格氏试剂中,
步骤六:加热反应后,得硫化产物,冷却后加入NH4Cl溶液,
步骤七:用盐酸酸化,再经二氯甲烷萃取,合并有机相,干燥过滤,减压蒸出溶剂得到的粗产物
步骤八:用乙醇提取,蒸干溶剂,得产物.
金纳米晶诱导(修饰|链接)双巯基偶氮苯/Azobenzene复合定制材料
在制备金纳米链接巯基偶氮苯中,使用CTAC作为表面活性剂制备的金种子合成了60-255纳米尺寸可控的、单分散的具有{331}晶面的二十四面体金纳米晶。发现{331}晶面的二十四面体金纳米晶的电催化性能和表面增强拉曼性能都具有尺寸依赖性。纳米多孔金(0.088 mA cm-2)[4]相比,尺寸为110纳米的{331}晶面的二十四面体金纳米晶在碱性条件下甲醇氧化方面表现出**的催化活性(0.178 mA cm-2),这归因于颗粒表面高密度的原子台阶、纽结等缺陷的存在。以对氨基苯硫酚作为探针分子,175纳米的{331}晶面的二十四面体金纳米晶表现出较高的表面增强拉曼活性。此外,在拉曼增强测试过程中,由于{331}高指数晶面对对氨基苯硫酚分子的激光诱导转变使之在二十四面体表面形成对二巯基偶氮苯(DMAB)。
货期:定制需7-14天,部分现货库存,下单可及时发货。
储藏方法 常温
型号 分析纯
用途范围 优级纯GR
产品等级 优级品
以上产品源于西安齐岳生物科技有限公司如有其他信息或产品信息咨询我们。
温馨提示:西安齐岳生物供应产品仅用于科研,不能用于人体!
小编:wyf 03.17




齐岳微信公众号
官方微信
库存查询